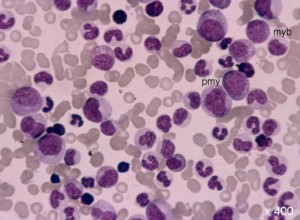
Kronik-Granülositik-Lösemi

Kan tahlili raporlarında karşılaştığımız bazı terimlerin anlamlarını merak ediyoruz. Granülosit yüksekliği kan testleri ve bazen bir kemik iliği biyopsisi yapıldığında teşhis edebilir. Kan değerlerinde karşılaşılan Granülosit ne demektir?
Granülosit, lökositlerin (akyuvarların) bir bölümünü oluşturan çeşitli hücre tiplerinin adıdır. Bu ismi almalarının nedeni granülosit hücre tiplerinin sitoplazmalarında bulunan farklı boyama özelliklerine sahip granüllerdir.
Kan tahlillerinde “Beyaz küre” de denen Granülosit yüksekliği ne anlama gelir?
Kronik miyeloid lösemi ya da kronik miyelositik lösemi olarak da adlandırılan kronik granülositik lösemi (KGL), granülosit olarak adlandırılan beyaz kan hücrelerinin kemik iliğinde kontrol edilemez bir biçimde çoğalmasıdır. Lösemik hücreler, akut granülositik lösemide olduklarından daha çok olgundurlar.
Kan dolaşımınızdaki granülosit seviyesi çarpıcı bir biçimde artar. KGL, özellikle 50 yaş üzerindekilerde daha fazla görülür. Her yıl yaklaşık olarak 5,000 kişiyi etkiler. Nükleer. & radyasyondan sağ çıkan (kurtulan) E kişiler gibi radyasyona maruz kalmış olan kişiler daha fazla risk altındadır.
SEMPTOMLAR
KGL’ nin iki aşaması vardır. Daha hafif aşamada semptomlar olmayabilir. Bazı kişiler gribe benzer semptomlar yaşarlar; kendilerini genellikle yorgun hissederler. Biraz yorulduklarında nefes darlığı yaşarlar. Aynı zamanda, karınlarının sol üst kısmında büyümüş dalaktan kaynaklanan bir ağrı ya da bir baskı hissi de olabilir. Geceleri terleme, kilo kaybı ve anemi diğer yaygın semptomlardır.
KGL’ li çoğu kişi, 3 ila 5 yıl sonra (“blast transformasyonu” olarak adlandırılan) semptomları akut granülosistik lösemininkine paralel olan (kan, olgunlaşmamış beyaz kan hücreleri olan blast hücrelerle dolduğundan “blast transformasyonu” olarak adlandırılan) daha şiddetli bir aşamaya girerler.
Kronik Granülositik Lösemi Tedavisi
Kan testleri ve bazen bir kemik iliği biyopsisi ile teşhis edilen KGL, kan ve kemik iliğinde artmış sayıda granülosit ve Philadelphia kromozumunun bulunması teşhisi doğrular.
Tablet ya da enjeksiyonlar halinde verilen kemoterapi, ayakta tedavi bazında uygulanır. Kemoterapi, semptomları ortadan kaldım ve kemik iliğinin yeniden normal miktarlarda sağlıklı hücreler üretmeye başlamasına olanak sağlar. Doktorunuz, ilacın kan sayımınız üzerinde arzulanan etkiyi yarattığından emin olmak için kanınızı gözlemleyecek ve ilacınızı ayarlayacaktır.